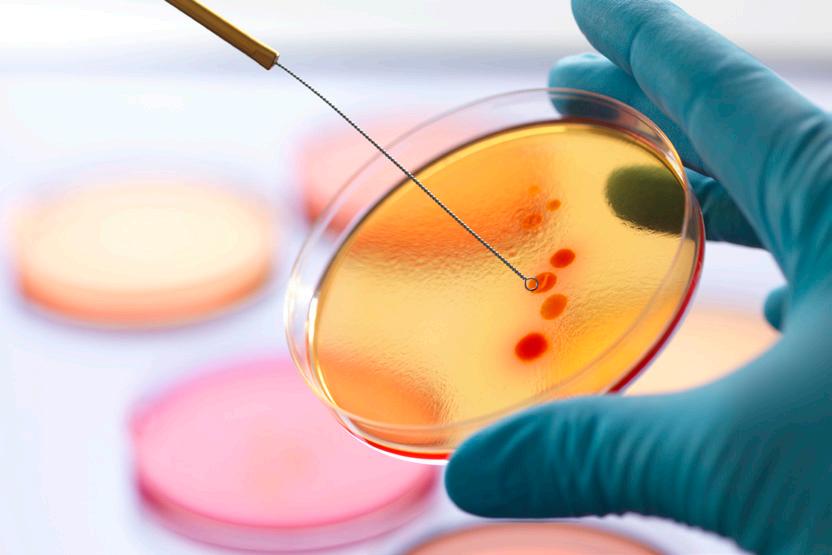

Aussie healthcare pioneers are leading the way to a brave new world

From medtech minnows to biotech behemoths, ASX healthcare firms are on the rise
NADINE MCGRATH
In an era when people are increasingly concerned about ethical investing, or using their money for increasing personal wealth and for the greater good, healthcare is a market sector that stands out.
And it’s comprised of several interesting sub-sectors, including pharmaceuticals, medical devices, health services and health technology, where use cases and benefits of artificial intelligence have become a focal point. Companies in this sector have potential to save lives and improve quality of life through better diagnoses, development of novel treatments, or advancement of standards of care.
In Australia, we have a long, proud history in healthcare and medical research, which has included Nobel Prizes in Physiology or Medicine.
We are ranked seventh in the

world in medical research, with strong support from industry and government ensuring we continue to shine in an area of global importance.
To capitalise on our worldleading research, the federal government is prioritising and spending big on Australian-made to grow our medical manufacturing capabilities.
Government and industry leaders believe Australia has the potential to become a global force in manufacturing of healthcare and medical products. However, the healthcare sector has unique challenges and risks.
Discoveries can take years to reach clinical trials, regulatory approval and commercialisation, while the landscape is filled with ideas that, for various reasons, didn’t succeed.
But when new treatments or medical devices are successfully developed and commercialised, this can bring big investor returns.
“To capitalise on our world-leading research, the federal government is ... spending big.”

Publisher: Stockhead
Co-Editor: Rob Badman
Co-Editor: Gregor Stronach
Co-Editor: Nadine McGrath
Contributors: Tim Boreham Scott Power
The ASX healthcare sector is home to companies ranging in size and scope, from the large and established to those in early stages of research and development, providing a range of opportunities for investors based on time frame and risk tolerance.
Our biggest company on the ASX health index, CSL, was founded in 1916 as Commonwealth Serum Laboratories, an Australian government body to service the needs of Australia isolated by war, before being incorporated in 1991 and listing on the local bourse in 1994.
Behind ASX healthcare companies – big and small – are some brilliant and passionate people, determined to advance their focus areas. At Stockhead, we’re here to tell the stories and keep investors informed about this growing and vibrant sector. ■
E: advertise@stockhead.com.au

Investor
The ASX-listed companies in the race to be next big biotech winners
Led by the small to mid-sized plays, the ASX-listed biotech sector is fast emerging from its post-pandemic nuclear winter as drug and device developers show tangible signs of progress after years of development.
Dozens of companies are in late-stage trials, while some have achieved the holy grail of local or US regulatory approval.
If there’s a definitive turning point for drug developers, it was the March 2023 decision by the US Food and Drug Administration (FDA) to approve Neuren Pharmaceuticals’ Daybue, to treat the rare childhood disorder Rett Syndrome.
The approval elevated Neuren from a $50 million stock years ago to a $2.5 billion valuation.
In late 2022, the then junior Telix Pharmaceuticals won FDA approval for its radio imaging tool Illuccix, to diagnose prostate cancer. The company is now worth more than $6 billion.
In a more niche vein, Botanix in June this year won FDA approval for Sofdra, a drug to alleviate excessive sweating.
On the same day, minnow Control Bionics announced the local Therapeutics Goods Administration
had green lighted Drove, a wheelchair module that enabled users to control actions with brain signals alone.
Next Neuren? Next Telix?
A fast-following Melbourne Cupsized field is emerging to become ‘the next Neuren’ of drug discovery, or the ‘next Telix’ of the diagnosis world.


tricky left ventricle.
Among the most advanced drug plays, Opthea has completed enrolment of two pivotal Phase-III studies to treat wet aged related macular degeneration with its novel compound. Top-line results are expected next year.
Dimerix shares soared in March after the company announced positive interim results for its PhaseIII trial to treat the kidney disorder focal glomerulosclerosis.
Paradigm Biopharmaceuticals expects to launch a pivotal Phase-III trial, to test its repurposed drug for knee osteoarthritis. The company is eyeing both FDA assent and early provisional marketing approval from the local Therapeutic Goods Administration (TGA).
Meanwhile EBR Systems is preparing to lodge an application to the FDA for pre-marketing approval of Wise, a leadless device that promises to revolutionise cardiac resynchronisation therapy of the
Still on hearts, Imricor has launched a trial of its ablation device, to support its goal of FDA approval in 2025.
And just to show the sector really is up and about, LTR Pharma expects a completed small, successful trial to support early TGA approval for its disruptive spray-based erectile dysfunction treatment, Spontan.
While medical devices usually offer a cheaper and quicker route to market, drug development is notoriously expensive.
As is the case with Neuren, the process can take decades but the rash of recent capital raisings show that investors see an endgame in sight.
Unlike in previous years, the surge of interest in life sciences is more evident in the emerging companies than the sector’s well-established Big Three: CSL, Cochlear and ResMed.
AI could boom biotech Industry newsletter Biotech Daily’s index of the most substantive 40
biotechs – but excluding the Big Three – shows the sector’s market cap surged to a record $33.7 billion at the end of June, up 61 per cent year-on-year.
In contrast, the Big Three gained a more sedate 4.6 per cent, to $206 billion.
Has the boom only just begun?
The portfolio manager of SG Hiscock’s Medical Technology Fund, Rory Hunter points to the “potentially generational opportunity” of artificial intelligence in the healthcare sector, which already is being manifested in “seemingly endless” applications.
“Many regulatory and ethical issues will have to be addressed along the way,” he says.
“However, this technology has the potential to tackle some of the most significant challenges set to be faced by global governments and populations in the coming decades.” ■
Four reasons the healthcare sector is showing vitality
Historically, the ASX healthcare sector has delivered strong performance for investors.
The S&P/ASX 200 Health Care index outperformed the benchmark S&P/ASX 200 index in seven of the past 10 years, delivering a CAGR of 11.9% compared to 8.1%.
As inflation rose, the ASX healthcare sector struggled, but come October 2023 signs of improving investor sentiment emerged. Looking forward, the outlook feels very positive.
Inflation has been sticky and interest rates higher for longer than forecast. However, as rates come down and economic conditions improve, money is expected to continue to flow into the stock market and the emerging healthcare space.
Strong backing for life sciences and biotech
The Australian life sciences ecosystem is worth more than $8 billion in annual revenue and is projected to grow at 3% annually from 2021-2026.
Australia’s medical and biotechnology sector has benefited from a multimillion-dollar windfall of government funding and substantial tax breaks for companies investing in R&D.
Globally, the sector is projected to be worth around US$3.44 trillion by 2030, and the Federal Government is ensuring Australia will well and truly be at the party.



As of June 2024 there were 147 companies with a market capitalisation of $236 billion or more on the ASX, according to Bioshares.
The top 10 health stocks represent 94% of the total and include blood products giant CSL (ASX:CSL), Cochlear (ASX:COH) and Resmed (ASX:RMD).
As macroeconomic and geopolitical factors continue to impact equity markets, companies hitting major milestones – such as receiving regulatory approval,
achieving positive clinical results or securing material sales orders – are performing well.
Those in hot spaces, such as radiopharmaceuticals, are also performing strongly, while solid sales momentum, approaching profitability and leading-edge technologies also tend to move a share price higher.
The lucrative rare diseases market is also getting plenty of attention as investors come to understand the benefits of an orphan drug designation (ODD).
In the US perks include increased access to the US FDA, new drug application fee waivers, a potentially
faster route to market and seven additional years of exclusivity once a drug is approved.
In most cases, shares are being positively re-rated
After an extended period of underperformance, 2024 has seen several companies refresh management teams and boards or change or refocus strategy in an attempt to revitalise investor interest. In most cases shares are being positively re-rated.
On the M&A front, domestic and international activity has increased. Many larger pharmaceutical and medical device companies with strong post-Covid balance sheets are looking to bolster their portfolios, meaning M&A activity will likely continue throughout 2024.
AI emerging as a major healthcare theme
Artificial intelligence (AI) is also emerging as a theme for healthcare.
The Albanese government is investing $30 million in improving access to health services and maintaining Australia’s world class health system.
Healthcare has historically lagged in technology adoption, but the healthcare system’s inherent constraints offer a compelling case for a significant role for AI in the sector’s future.
Labour shortages and budgetary pressures are changing current practices, with software being introduced to optimise workflow, enhance scheduling, coordinate care and fortify data security.
Also, drug development will likely benefit through shorter development times and improved patient selection, resulting in reduced costs and increasing the number of drugs in the pipeline. ■
◾ Scott Power – a senior analyst with Morgans for over 27 years
Molecular biologist and investment analyst
Dr Bianca Ogden shares her insight in the sector
Healthcare has no shortage of companies developing products designed to radically change lives. And when milestones are met on the way to commercialisation, significant financial returns can result.
With that in mind, what should investors consider when scanning the sector?
As portfolio manager of the Platinum International Health Sciences Fund since 2007, leading the asset manager’s healthcare sector team, Dr Bianca Ogden is the perfect person for Stockhead to ask.
The molecular biologist and investment analyst has worked for some of the world’s major pharmaceutical companies including Novartis and Johnson & Johnson, making her uniquely positioned to understand fundamentals of healthcare companies and identify those with a solid foundation in scientific research.
“One of the things people have to decide for themselves is if they want to invest or whether they actually just want to punt,” says Ogden.
“There are long lead times in the sector and it requires a lot of capital to come up with, say, the next standard of care for a condition.
“If you invest you have to dig in
deep and don’t get worried about the short-term volatility or noise.”
Catalysts for healthcare companies, such as clinical trial results or regulatory approvals, can move a share price significantly up and down.
For Ogden, these are the inflection points that can –depending on outcomes – represent clear markers for either making an investment in a company or avoiding or reducing exposure.
“These are data points, which are obviously important because the company (and investors) can see if a drug is matching expectations,” Ogden says.
“For me, catalysts are inflection points that help me decide whether to put more money in, consider if the valuation is still reasonable and determine if the risk benefit still makes sense.”
There is nothing necessarily wrong with taking a shorterterm ‘punter’ view and looking to capitalise on catalysts in healthcare companies, notes the doctor, adding:
“If you’re just about catalysts –and a lot of people are with a shortterm horizon – then they go in and



out of a company.”
“I run a long-term-oriented specialist fund. And it is all about supporting these companies along their journey and often taking advantage of low valuations due to lack of news flow/catalysts.”
Investing, not punting, in the healthcare sector is about understanding a company and how the management team is translating the science into new therapies, believes Ogden.
“We look at the science in detail,” she explains.
“Is the hypothesis sound? Is there some rationality behind it? Have other scientists worked on a similar idea, therapeutic target?”
“If you invest you have to dig in deep and don’t get worried about the short-term volatility or noise.”
Ogden notes that while many companies will present sound theories and show sound results in cell culture and animal studies, in the end it comes down to results in human clinical trials.
“We look at the team, who is behind a company, what have they done in previous careers. Do they understand the downside, and do


they know how to design clinical trials?
“A lot of people don’t consider the global competitive landscape. This is paramount these days as many therapeutic indications, especially oncology is highly competitive.
“If you are just looking to play a catalyst it may not matter as much, but often the share price spike upon positive data tends to be very short lived if the data is not competitive on a global scale.”
Ogden adds that for longterm investors it is paramount to understand this competitive environment globally and often that requires a lot of diligence.
“There is a lot going on in private and listed companies and so what we do – we map that quite intensively to really understand what is going on.
“Talking to investor peers and physicians in the field is crucial in this endeavour.
“We might look at how company X has designed their clinical trial… What do clinicians want? Because ultimately, they’re the customer and so how does all this fit with company A, which you are considering as an investment?”
Healthcare is a fluid sector, she notes, with new data being released constantly.
“It’s not just the clinical trial data from company A, in the end it is about how the data holds up in the competitive landscape.”
Getting a new drug or medical device to market is big bucks, involving R&D, clinical trials and regulatory approval.
“We spend a lot of time talking to companies, trying to get to know the teams. What is their plan B, how and when will they raise capital, how much funding do they need?” says Ogden.
“We try to understand if they have planned for various scenarios and I always like to look at what companies did when something didn’t work – their behaviour and how they dug themselves out of a black hole.”
And looking at a healthcare company’s valuation is important, too, but the doctor caveats that it can be a tricky area for investors.
“They often don’t have earnings and spend a lot of money, so
determining why company X is worth billions while Y is in the millions can be difficult,” Ogden says.
“That comes again from looking at the whole opportunity set in this space and where everyone is in development.”
Ogden explains that what it essentially comes down to is how much cash a company has on the balance sheet, as that can be a differentiating factor when it comes to accelerating a promising program or expanding patient recruitment.
“If a company only has five people in a Phase-I trial while another has 30, that is quite a difference so you may also try and weigh that up,” she notes.
Like other sectors of the equity market such as materials (think lithium and rare earths), Ogden says that sometimes subsectors of the healthcare industry can also be hyped up.
“We have recently seen a lot of excitement in radiotherapy, an area we have been interested in for the
past two decades.
“A lot of money has flown into companies in this space and valuations have expanded quite a bit to a level that is probably a bit stretched.”
And over the past year, the doctor confirms, a lot of excitement has started to build for cell therapy for inflammatory diseases.
“In recent weeks we have seen some clinical data that is promising but also highlighted that this field is at its infancy and requires a lot more work,” she says, adding:
“Considering valuation on a global scale is very important.”
It’s also not just about the science when investing in the healthcare sector – commercial viability is just as, if not more, important. For example, Ogden notes:
“Gene therapies for haemophilia are scientifically very exciting but so far commercial traction of the approved products has been limited given there are other good drugs available.”
“Science is great but on the commercial side, to get reimbursement is not as easy and straightforward.”
Often if a smaller company has a partnership with another big pharma company, many consider that a validation of the small company’s approach, suggests Ogden.
“When I read the word de-risk it doesn’t mean anything to me because big pharma companies can get it wrong, too,” she said, adding that investing in a biotech is akin to attempting to solve a puzzle.
“You try and find all these puzzle pieces and put them together.
“You’re a bit of a detective, trying to decipher what is really going on in a company or in a therapeutic area.” ■
Fuelled by hefty federal government backing, Australian healthcare and biotech innovation is thriving. Positive balance sheets, strong roadmaps and potential opportunities for investors abound. Here are the companies at the forefront of a robust sector.

AdAlta (1AD)
Aroa Biosurgery (ARX)
Avecho Biotechnology (AVE)
Bioxyne (BXN)
Chimeric Therapeutics (CHM)
EBR Systems (EBR)
Emyria (EMD)
Imricor Medical Systems (IMR)
Imugene (IMU)
Inoviq (IIQ)
LTR Pharma (LTP)
Neurotech International (NTI)
Nova Eye (EYE)
Opthea (OPT)
Optiscan (OIL)
PainChek (PCK)
Paradigm Biopharmaceuticals (PAR)
Percheron Therapeutics (PER)
PharmAust (PAA)
Race Oncology (RAC)
Syntara (SNT)
Trajan Group Holdings (TRJ)

TIM OLDHAM CEO & MANAGING DIRECTOR
◾ Company Name: AdAlta
◾ Company ASX code: 1AD
◾ Key areas: Clinical stage biotechnology
◾ Key Personnel: Tim Oldham, CEO & Managing Director
◾ Market Cap as of 31 July 2024: $14.89M
◾ 52 Week share price low/high: $0.017 - $0.041
◾ Website: adalta.com.au
With a little help from the ocean’s apex predator, AdAlta is on a mission to develop better treatments for some of the most difficult fibrotic diseases and solid cancers.
The company’s lead program uses i-bodies to tackle idiopathic pulmonary fibrosis (IPF), a fatal lung disease that affects half a million people globally –‘Idiopathic’ meaning that the source of the disease is not known.
AdAlta is also delving into the popular emerging field of CAR-T cancer immunotherapies, but with a unique Asia-focused strategy.
“AdAlta is also delving into the popular emerging field of CAR-T cancer immunotherapies, but with a unique Asia-focused strategy.”
“Our i-body platform has the capability to do things that antibody drugs can’t,” says AdAlta CEO Tim Oldham. “But we have two distinct assets that attract different kinds of investors.”
AdAlta’s i-bodies mimic the cell characteristics of hardy and adaptive sharks. The company’s lead molecule, AD-214 is engineered with two ‘loops’ that latch onto proteins over-expressed in unhealthy tissue.
Having completed a Phase-I study confirming the safety and tolerability of AD-214 in healthy volunteers, AdAlta is preparing for a global Phase-II trial to test the efficacy of the compound on approximately 150 IPF sufferers.
Oldham acknowledges the circa $50 million cost of the trial is beyond the company’s reach. Its solution is to form a subsidiary, AdSolis, with the remit of raising private funds specifically for the IPF program.
While a traditional big pharma partnership is not off limits, Oldham says, “the more likely strategy is we will bring a syndicate of third-party strategic and financial partners into the private vehicle.”
That way, AdAlta unlocks the value of the asset “which we don’t think is reflected in our share price today.”
Resolving not to preside over a oneasset company, management looked at other areas in which its i-bodies could make a distinctive therapeutic difference.
“We realised that combining the unique targeting of i-bodies with CAR-T cells could produce a more potent therapy for solid cancers,” Oldham says.
The company formed a separate arm, AdCella, in alliance with local venture capitalist SYNthesis BioVentures.
The agreement involves the parties identifying and acquiring cellular therapy assets in Asia, particularly China, where half of the world’s work in that field takes place.
“We are doing due diligence on ten assets, with a view to licensing between one and three of them over the next six months or so,” Oldham says.
Currently AdAlta owns 75% of AdCella (SYNthesis BioVentures owns the remainder), but this reverts to more like a 50:50 split after the parties equally chip in equal initial funding.
By acquiring overlooked early-stage programs, the venture will enable assets that already have clinical data behind them to be progressed in Australia under western regulatory standards.
“We are getting really good feedback from investors because we are not trawling the US for assets that everyone has looked over already,” Oldham says.
And while IPF partnering momentum builds, the therapeutic need for the ‘orphan’ indication is clear and present.
“We have half a million people around the world facing a death sentence because there is no good therapy for them,” Oldham says.



DR BRIAN WARD FOUNDER & CEO
◾ Company Name: Aroa Biosurgery
◾ Company ASX code: ARX
◾ Key areas: Wound care, soft tissue regeneration
◾ Key Personnel: Dr Brian Ward, Founder & CEO
| James Agnew, CFO
◾ Market Cap as of 31 July 2024: $216.85M
◾ 52 Week share price low/high: $0.475 - $0.930
◾ Website: aroa.com
When it comes to wounds and soft tissue reconstruction, the New Zealand based Aroa Biosurgery has the attendant problems covered – literally – with its devices that expedite the healing process.
At Aroa’s core is its extracellular matrix (ECM) platform, based on a rich and complex mix of biological molecules sourced from the stomach of sheep.
Aroa was founded in 2008 by Kiwi veterinarian Dr Brian Ward, who discovered that the gut linings of the ruminants was ideal healing material for soft tissue regeneration.
“We get fast regrowth and very well
“Aroa’s pioneering device, Endoform, is used for non-healing wounds such as diabetic and venous foot ulcers.”
revascularised tissue,” he says. “We don’t seem to see the infection complications or adverse immune responses seen with other products.”
While Aroa’s devices are sold in 15 countries, the company is focused on the key US market which accounts for more than 90% of its sales.
Aroa’s pioneering device, Endoform, is used for non-healing wounds such as diabetic and venous foot ulcers.
Other products are Myriad Matrix (soft tissue reconstruction), Ovitex (reinforced scaffold for hernia abdominal wall reconstruction) and Ovitex PRS (plastic surgery such as breast reconstruction).
A more recent product, Symphony is a skin substitute product for complex wounds (diabetic foot and venous leg ulcers).
Covering the Ovitex range, Aroa has an alliance with the Nasdaq-listed Telia Bio. Under the revenue sharing arrangement, Tela is responsible for product sales and some development costs.
Ward cites a total US addressable market of $US3 billion, including $US1 billion for Symphony and ulcers and $US730 million for Myriad. Plastic surgery is an additional $US700 million opportunity.
Myriad sales grew by over 70% in the year to March 2024 and accounted for about one-third of Aroa’s total revenue of $NZ69.1 million.
To date, over six million Aroa products have been applied in a range of procedures globally. The devices have been validated across multiple clinical trials, including a hernia study that produced “transformational” results.
“Typical recurrence rates are in the
10 to 30% range, but [our] recurrences were less than 3%,” Ward says.
This year, the company expects to report interim results from an 130-patient trial for lower limb salvage, as well as a similar-sized trial of the use of Symphony for diabetic and venous ulcers.
Aroa is also developing Enivo, which combines an implant and a catheter and pump. A vacuum is delivered into deep soft tissue, enabling it to be held together while healing takes place.
“It will be used where surgeons have dissected tissue to access a surgical site, or have removed tissue in cancer surgery,” Ward says.
While Aroa made an underlying (EBITDA) loss of $NZ3.09 million in 2023-24, the company would have been profitable excluding $2-6 million of Enivo development costs.
Management has guided to revenue of $NZ80-87 million for the current financial year and EBITDA of $2-6 million.
Ward says the company’s new Auckland facility supports annual revenue of $NZ200 million, which means the company can more than double output without any more investment.



PAUL GAVIN CHIEF EXECUTIVE OFFICER
◾ Company Name: Avecho Biotechnology
◾ Company ASX code: AVE
◾ Key areas: Phase-III trial in mental health
◾ Key Personnel: Paul Gavin, CEO | Dr Roksan Libinaki, COO
◾ Market Cap as of 31 July 2024: $7.92M
◾ 52 Week share price low/high: $0.002 - $0.009
◾ Website: avecho.com.au
For millions of chronic insomniacs, counting sheep does not lead to the land of nod, while other non-prescription therapies such as melatonin are equally ineffective.
The sleep-inducing properties of cannabis have been known for hundreds of years – but formal evidence is needed. To achieve this, Avecho Biotechnology has launched a late-stage Phase-III clinical trial to validate the efficacy of its proposed cannabidiol (CBD) based insomnia treatment.
Avecho CEO Paul Gavin says getting a cannabidiol drug to market as a registered pharmaceutical is easier said
“There’s a direct link between sleep deficit and depression and anxiety – two indications commonly targeted by CBD drug developers.”
than done, with three local Phase-III insomnia trials failing.
A key impediment is that when administered orally, CBD is not easily absorbed with only 6% of the dose finding its way to the bloodstream.
Cannabidiols are also chemically unstable, so developers need to satisfy regulatory requirements of a minimum two-year shelf life.
Avecho has developed a compound called tocopheryl phosphate mixture – TPM – which improves drug solubility and absorption. The proposed treatment combines TPM with synthetic cannabidiol in a soft-gel capsule (without the psychoactive agent THC).
Carried out across five cities locally, the pivotal Phase-III trial is aimed at securing Therapeutics Goods Administration (TGA) approval as an over-the-counter product that can be sold by chemists without a prescription.
“The trial is the largest study of its kind for assessing cannabidiol for insomnia in Australia,” Gavin says.
In a February meeting with the TGA, the agency described the trial design plan as “well thought-out and robust”.
As well as satisfying the TGA’s overthe-counter requirements, the trial is designed to meet the standards of other regulators including the US Food & Drug Administration and the European Medicines Agency.
The study aims to recruit 519 candidates across five Australian sites, with the participants administered nightly doses of 75mg or 150mg (or a placebo).
Early next year Avecho expects to complete an interim analysis of the first 219 patients.
The company estimates that 10-30%
of the populace is affected by insomnia, about 10-15% chronically.
There’s a direct link between sleep deficit and depression and anxiety – two indications commonly targeted by CBD drug developers.
Avecho is also eyeing the multibillion dollar US recreational and pain management cannabis market, where it plans to partner with North American companies to sell TPM-infused ‘gummies’ that reduce the activation time of the THC from an hour or more to ten minutes.
This is crucial because users often take multiple gummies before the effect kicks in, leading to adverse effects.
Late last year the company raised $8 million to commence the Phase-III program but will need further capital to complete the entire study. Currently Avecho has a market valuation of less than $10 million, compared with several hundred million for other ASX-listed, Phase-III drug developers.
But Gavin says assuming a successful Phase-III trial, the company is likely to benefit from a significant re-rate.
“That makes for a great buying opportunity in our view.”



SAMUEL WATSON MANAGING DIRECTOR & FOUNDER
◾ Company Name: Bioxyne
◾ Company ASX code: BXN
◾ Key areas: Biotechnology, investigational and psychoactive medicines manufacturer
◾ Key Personnel: Samuel Watson, Managing Director & Founder | Jason Stephens, General Manager | Jason Hine, COO
◾ Market Cap as of 31 July 2024: $12.27M
◾ 52 Week share price low/high: $0.004 - $0.021
◾ Website: bioxyne.com
Under the leadership of founder and CEO Sam Watson, Bioxyne is committed to navigating the emerging psychedelic and cannabis sectors with “rigor and integrity”.
Watson is concerned about the potential pitfalls of these burgeoning industries, such as improper dosages, impure substances, and the lack of medical supervision – all which can lead to severe psychological and physical harm.
Bioxyne stands out by adhering to Good Manufacturing Practices (GMP) certification, ensuring stringent standards from raw material sourcing to
“In February this year Bioxyne received an Australian GMP licence for psilocybin, MDMA and medicinal cannabis. ”
final product testing.
Historically known for pioneering consumer health products such as probiotic dairy immune supplements, Bioxyne has significantly evolved.
The company’s transformation accelerated in May last year with the acquisition of Breathe Life Sciences (BLS), founded by Watson, through a scrip deal.
Operating across Australia, Europe, the UK, and Japan, BLS has established a strong global presence in the medicinal cannabis and food supplements markets under the Dr Watson and Breathe Life Sciences brands.
In February this year Bioxyne received an Australian GMP licence for psilocybin, MDMA and medicinal cannabis. This makes the company the only licensed Australian manufacturer of these substances, either as active pharmaceutical ingredients (API) or in final-dose form for patients.
The first batch of these materials is set to be produced at their South Brisbane facility.
MDMA (commonly known as molly or ecstasy) and psilocybin (magic mushrooms) are the next frontier in mental health therapies, showing promise in treating conditions such as post-traumatic stress disorder, depression, and pain.
Bioxyne’s ambitions have been bolstered by the local Therapeutic Goods Administration’s decision last year to reclassify MDMA and psilocybin from prohibited substances to controlled drug status.
This regulatory shift enables patient treatment under the Authorised Prescriber Scheme (APS), similar to medical cannabis.
While medical cannabis remains Bioxyne’s primary growth driver in the short term, the company’s capital-
light model allows it to source the best genetics and cannabis from global growers at competitive prices.
Bioxyne is licensed to produce various medical cannabis forms, including vapes, THC (tetrahydrocannabinol) oil, flowers, and gummies.
Notably, Bioxyne plans to introduce locally-made gummy pastilles to the Australian market, a popular delivery medium in the US and Canada where they account for approximately 30% of cannabis sales.
Bioxyne aims to become the leading supplier of psilocybin and MDMA for clinical trials and authorised prescribers by 2025.
Although only a few patients have been treated with psychedelics under the APS to date, Watson anticipates a significant increase in the coming months, potentially reaching hundreds or even thousands of patients.
Bioxyne generated revenue of $9.43 million in the year to June 30 2024, with 50-60% derived from global medicinal cannabis sales. Management targets $50 million of turnover within three years. With the Australian medical cannabis market heading towards $1 billion annually, Watson says the company is “well positioned” to capture at least 10% of that market.



DR REBECCA McQUALTER CHIEF OPERATING OFFICER
ASX:CHM
◾ Company Name: Chimeric Therapeutics
◾ Company ASX code: CHM
◾ Key areas: Biotechnology – clinical stage cell therapy
◾ Key Personnel: Dr Rebecca McQualter, COO
◾ Market Cap as of 31 July 2024: $18.39M
◾ 52 Week share price low/high: $0.016 - $0.047
◾ Website: chimerictherapeutics.com
The new head of cancer drug developer Chimeric Therapeutics, Dr Rebecca McQualter acknowledges that investor interest in cancer cell therapies has waned because developers of current marketed drugs have not met expectations.
“They have been in the market for ten years and are yet to live up to their full potential,” she says.
With Chimeric’s share price sagging since its January 2021 listing, McQualter was hired to review the commerciality of the company’s clinical programs and reduce cash burn.
“My remit is to take a look and ensure
“Chimeric’s work revolves around CAR-T therapies, which involve genetically engineering t-cells to improve the immune system’s ability to fight cancers.”
that everything makes sense,” she says.
Chimeric’s work revolves around CAR-T therapies, which involve genetically engineering t-cells to improve the immune system’s ability to fight cancers.
While several CAR-T drugs have been approved for blood cancers, solid cancers are uncharted territory. It’s no coincidence that Chimeric’s three key programs are focused on the latter, with an ancillary acute myeloid leukemia (AML) trial.
Chimeric listed on the back of a chlorotoxin (CLTX) that derives from the synthesised venom of the deathstalker scorpion. CLTX binds to biomarkers and is well known as an in oncolytic imaging agent.
This legacy program focused on patients with glioblastoma, a hard-totreat brain cancer.
However a separate program for gastric, pancreatic and colorectal cancers, CHM-CDH17, has emerged as a key priority.
Acquired from the University of Pennsylvania, CHM-CDH17 targets CDH17, an antigen expressed on tumors. Having seen encouraging results in preclinical (mouse) models, the company has launched a Phase-1/2 trial at Nashville’s Sarah Cannon Cancer Centre, with more sites to open.
McQualter says the program is scalable and addresses a high unmet need, especially with more young people being diagnosed with colorectal cancer.
A separate Chimeric program focuses on so-called ‘natural killer’ NK cells, in alliance with Ohio’s Case Western Reserve University.
The allogeneic (off-the-shelf) therapy involves a healthy donor providing
the material, from which the cells are produced.
The company has two 1b trials open for colorectal cancers and AML, at Ohio’s Case Western Reserve University and the MD Anderson Cancer Centre in Texas.
Earlier, a nine-patient phase 1 study established safety across three dosing levels.
McQualter says the glioblastoma program involves “beautiful science”. The procedure involves an injection to the brain at the cancer site.
With a degree in cell therapy from Monash University, McQualter was headhunted by Chimeric founder and chairman Paul Hopper to tap the leading Australian stem cell community and secure local clinical sites.
McQualter has extensive senior commercial healthcare experience, most recently at Novartis Australia.
“It’s really important that as we are an ASX-listed company, Australians who need it can take advantage of the great tech that we have,” she says.
Meanwhile, investors can expect preliminary data from the CDH17 glioblastoma study and the NK AML programs by the end of 2024.



JOHN McCUTCHEON PRESIDENT & CEO
◾ Company Name: EBR Systems
◾ Company ASX code: EBR
◾ Key areas: Medical technology – cardiac rhythm
◾ Key Personnel: John McCutcheon, President & CEO
◾ Market Cap as of 31 July 2024: $354.33M
◾ 52 Week share price low/high : $0.535 - $1.200
◾ Website: ebrsystemsinc.com
Heart pacemakers have been around for years, but to date no-one has been able to solve the bodily plumbing problem of accessing the left ventricle with the requisite leads.
The left ventricle circulates arterial blood straight to the brain, while the right side (venous blood) circulates through the lungs.
Because the left-side leads are more likely to create a clot, they are currently placed in the surrounding coronary sinus and the stimulation – known as cardiac resynchronisation therapy, or CRT – occurs outside the chamber.
Failure rates for these leads are high.
“McCutcheon estimates a US market of approximately 80,000 patients who are unable to receive lead-based devices.”
The US based, ASX-listed EBR Systems has perfected a leadless device to enable CRT of the tricky left ventricle.
The size of a grain of cooked rice, the Wise device – as in ‘wireless stimulation endocardially’ – is embedded in the heart and powered by a subcutaneous battery close to the heart.
An unobtrusive implanted transmitter picks up the groove of the right ventricle and sends a signal to the Wise electrode, which converts ultrasound energy to electrical energy to stimulate the left ventricle.
EBR is readying Wise for a premarket approval application to the US Food & Drug Administration (FDA), under the fast-track and breakthrough drug designation pathways.
FDA assent is expected in the September 2024 quarter, with the company targeting approval – and commercialisation – in the March quarter of 2025.
More than 400 high-risk patients have been embedded with the device to date, with the first Australian patient implanted in February 2018.
Earlier, Wise gained European (CE Mark) approval, but the device regulations have since been tightened there and the company is focused on the US market.
Beyond that, the Australian Therapeutics Goods Administration is likely to be the next port of call.
“The Australian market is relatively small, but we have key opinion leaders [clinicians] who were involved in our early pivotal trial,” McCutcheon says. “So Australia still has global importance to us.”
In May 2023 EBR revealed its 183-patient Wise pivotal study easily
passed the key primary safety and efficacy endpoints.
These high-risk patients had failed previous treatments.
The study met its primary endpoints with the patients showing a 16.4% reduction in left ventricle end systolic volume, a sign of improved heart function.
McCutcheon estimates a US market of approximately 80,000 patients who are unable to receive lead-based devices, or who are at high risk from an upgrade procedure (from implanted pacemaker or defibrillator to lead-based CRT).
“It fills a unique part of the market and clinicians are desperate to see it launched so they can bring it to their patients,” he says.
McCutcheon says the company is addressing a potential US market of “many billions of dollars”, with current reimbursement codes supporting a price of $US45,000 ($68,000) per procedure.
McCutcheon describes EBR’s migration to the ASX as “happenstance”, driven in part by the shareholder base that includes prominent entrepreneur Mark Carnegie, Brandon Capital and industry super funds HESTA, Hostplus and Australian Super.


DR MICHAEL WINLO CEO & MANAGING DIRECTOR
◾ Company Name: Emyria
◾ Company ASX code: EMD
◾ Key areas: Medical technology and biotechnology – mental health
◾ Key Personnel: Dr Michael Winlo, CEO & Managing Director | Greg Hutchinson, NonExecutive Chairman | Sir John Tooke, NonExecutive Director
◾ Market Cap as of 31 July 2024: $16.97M
◾ 52 Week share price low/high: $0.040 - $0.124
◾ Website: emyria.com
The head of psychedelic-assisted treatment (PAT) pioneer Emyria, Dr Michael Winlo says the company’s history in medicinal cannabis has imbued it with the skills needed to succeed in the nascent sector.
These talents include treating and supporting patients, liaising with regulators and importing and handling controlled substances.
Emyria evolved from Emerald Clinics, a chain of specialist medicinal cannabis clinics that listed in 2020.
“Emyria’s current focus is on using MDMA (‘molly’, or ecstasy) to tackle treatment resistant post-traumatic stress disorder (PTSD).”
The company is now focused on researching and developing psychedelics to treat select mental health and neurological disorders.
“We thought the sector was more compelling [than medicinal cannabis] because of higher barriers to entry and more complex challenges that also increase the company’s potential,” Dr Winlo says.
Emyria’s current focus is on using MDMA (‘molly’, or ecstasy) to tackle treatment resistant post-traumatic stress disorder (PTSD).
About one million Australians suffer from PTSD, with about half of them treatment-resistant.
Emyria’s presence in the sector was cemented by last year’s purchase of Perth’s Pax Centre, a multi-disciplinary psychological trauma care service.
In April this year Emyria opened its own Empax Centre, the first of a planned rollout of bespoke treatment facilities.
Next to the Pax Centre, the facility has features such as low-stimulus spaces to ensure client privacy, advanced AV monitoring and AI- generated music for an “unparalleled therapeutic experience”.
Emyria’s fortunes have been spurred by the decision by the local Therapeutic Goods Administration (TGA) to reschedule MDMA and psilocybin (‘magic mushrooms’) from a prohibited substance to a controlled one.
This opened the way for the substances to be used not just in clinical trials, but under the Authorised Prescriber Scheme (APS). This means that – uniquely – Australian patients can access such unapproved treatment via accredited clinicians.
Currently, Emyria accounts for two of the country’s nine authorised prescribing psychiatrists – no mean feat given the hurdles to overcome.
Dr Winlo expects Empax to be a
centre not just for treating APS patients, but for sponsored research and the company’s own trial activity.
In conjunction with the charity Reach Wellness, the company is undertaking a 50-patient study of first responders with PTSD.
“So we have a variety of lanes open for participants to get access for free. But we also have the APS – in effect a ‘real world’ study – for those who can afford it.”
In October last year, Pax became the first Australian site to administer PAT after the TGA down-scheduling.
To date, eight treatment-resistant PTSD patients have been administered over 18 treatment sessions – with some “remarkable” early outcomes.
“Some patients have had full remission, and some are now seeking employment again, having been unable to work for years,” Dr Winlo says.
In April this year, Emyria raised $2.3 million in a placement, to support the Empax Centre rollout and research efforts.
“The big opportunity is for us to scale the service in a commercially viable way and use our early experience to support an ambitious innovation pipeline of better care models and our own novel drug treatments to tackle major unmet needs,” Dr Winlo says.



STEVE WEDAN PRESIDENT, CEO & BOARD CHAIR
ASX:IMR
◾ Company Name: Imricor Medical Systems
◾ Company ASX code: IMR
◾ Key areas: Medical technology – MRI-guided cardiac ablation
◾ Key Personnel: Steve Wedan, President, CEO & Board Chair | Nick Corkill, Vice President of Corporate Strategy
◾ Market Cap as of 31 July 2024: $146.38M
◾ 52 Week share price low/high: $0.397 - $0.809
◾ Website: imricor.com
Imricor Medical Systems Inc is seeking to improve common cardiac ablation procedures – not by re-inventing the operation itself, but by enabling cardiologists to be guided by magnetic resonance imaging (MRI) rather than traditional x-rays.
Imricor’s foundation product, VisionMR is the world’s first ablation catheter enabling MRI guidance, which offers superior imaging to x-rays without the use of harmful radiation and contrast dyes.
Cardiac ablation addresses heart arrhythmia, or irregular heartbeat,
“MRI-guided cardiac ablation offers superior soft-tissue contrast, enabling more precise visualisation of cardiac structures and targeting of “abnormal electrical pathways.”
manifested in right-side atrial flutter (AFL) or left-side atrial fibrillation (AF) or ventricular tachycardia (VT, rapid heartbeat).
Administered via a catheter in the vein, cardiac ablation creates tiny scars in the heart to block irregular electric signals and restore normal heartbeat. Vision-MR has been approved for AFL in 31 countries, notably Europe.
Based in the US medical device capital of Minnesota, Imricor is seeking US Food & Drug Administration (FDA) approval for the AFL indication, as well as European extension approval for VT ablations.
MRI-guided cardiac ablation offers superior soft-tissue contrast, enabling more precise visualisation of cardiac structures and targeting of “abnormal electrical pathways”.
Imricor is all about enabling better and safer procedures at the same cost (or less) than a conventional procedure.
“Because the clinicians currently can’t image the heart, they often have to hunt for the arrhythmia’s origin,” says Imricor founder and CEO Steve Wedan.
“Without MRI, they also can’t tell whether the tiny scars they intend to create will be permanent. Often patients go home, the scars heal, and the problem comes back.”
The US is especially attractive, accounting for about half of the $US8 billion global ablation market and offering attractive reimbursement.
To support its FDA application, Imricor is preparing for a 91-patient global trial, dubbed VISABL-AFL.
The trial is expected to complete this year, with FDA approval targeted for mid 2025.
While Imricor is providing a ‘better mousetrap’ for AFL ablation, Wedan founded the company in 2006 with the ultimate aim of improving the more
difficult left-side procedures.
Almost half of AF patients require a second procedure within five years.
“VT ablating is even harder, with long procedure times and only about a 50% success rate,” Wedan says. “We want to make it one of the most straightforward and successful procedures to do. We also expect to do it for far less cost per procedure.”
Dubbed VISABL-VT, a separate trial will support the company’s planned European application to expand approval to VT.
The company expects to enrol 64 patients across initial sites in the Netherlands and Germany.
Wedan says VT is becoming more prevalent because people are living longer.
“Ten years ago you wouldn’t see as many people needing VT ablations, but people are alive today with better cardiovascular care.”
While Vision-MR has been used in hundreds of procedures at five European hospitals, the company is reconnecting with customers after the pandemic hampered the sales rollout.
“The effects of the pandemic lasted much longer than the pandemic itself,” Wedan says.
“But our re-launch is underway, and with procedures like VT on the horizon we really expect to change the world.”



LESLIE CHONG CEO & MANAGING DIRECTOR
◾ Company Name: Imugene
◾ Company ASX code: IMU
◾ Key areas: Biotechnology – clinical stage immuno-oncology
◾ Key Personnel: Leslie Chong, CEO & Managing Director | Dr. Paul Woodard, Chief Medical Officer
◾ Market Cap as of 31 July 2024: $389.51M
◾ 52 Week share price low/high: $0.039 - $0.150
◾ Website: imugene.com
Immuno-oncology drug developer
Imugene has a complex work slate but a simple charter: to bring effective novel treatments to cancer patients with suboptimal treatments.
CEO Leslie Chong says the operative term is ‘novel’. Across its four key platforms, Imugene seeks to change the treatment paradigm – notably in the fast growing, US$3 billion-a-year CAR-T sector.
Imugene acquired its most advanced program, azer-cel, from Precision BioSciences of the US late last year.
A CAR-T therapy, azer-cel
“Imugene seeks to change the treatment paradigm – notably in the fast growing, US$3 billion-a-year CAR-T sector.”
“supercharges” the body’s T-cells to seek and destroy malignant cells expressing the biomarker CD19.
To date, the therapies have been autologous: white blood cells are extracted from patients and modified before being returned to the body. The process is costly and time-consuming.
In contrast, allogeneic, ‘off-the-shelf’ therapies are derived from healthy donor patients and can be shipped to clinics in multiple batches, making them available on demand.
Imugene could create history by getting the first allogeneic CAR-T drug to market. In a prior 84-patient Phase-I trial, azer-cel showed “strong safety and efficacy signals”.
In 18 patients who failed previous autologous CAR-T therapies for diffuse large B-cell lymphoma (DLBCL), an aggressive form of Non-Hodgkin’s lymphoma (NHL), azer-cel demonstrated an 83% overall response rate.
Preliminary data from its Phase-1b trial is expected in the second half of 2024.
Imugene has received US Food & Drug Administration (FDA) guidance on a potential Phase-II trial that could lead to US approval.
Currently there are limited options for patients who have failed multiple therapies. The company believes that if all goes well, potential marketing approval could be as early as 2026.
A separate clinical program, VAXINIA (CF33-hNIS), uses a chimeric vaccinia virus (CF33) to target metastatic advanced solid tumours.
Of the 40 evaluable patients in its trial dubbed MAST, nearly half have remained on treatment for more than 30 months and three patients have remained on treatment for more than 200 days.
A patient with bile tract cancer has maintained a complete response for more than 1.6 years and two patients with melanoma achieved partial responses.
Given the unmet need, Imugene has FDA fast-track status for bile tract cancer and has commenced a ten-patient expansion study. The company also plans an extension trial for bladder cancer.
Imugene’s third key program is onCARlytics (CF33-CD19). Known as OASIS, the relevant trial combines its onCARlytics virus with a CD19 drug to target solid cancers.
OnCARlytics causes solid cancer cells to display a CD19 marker on their surface, making them a target for CD19 drugs to kill them. Imugene also plans to combine onCARlytics with azer-cel.
Chong says achieving an effective CAR-T therapy for solid cancers is the “holy grail” of oncology.
“Only 10% of cancers are blood cancers while 90% are solid cancers,” she says. “If successful, onCARlytics could open up 90% of the market.”
Meanwhile Imugene’s cash balance of more than $100 million is adequate to fund the company to 2025 – beyond the short-term trial read-outs likely to pique investor interest.


Scan here for the company website

DR LEEARNE HINCH CHIEF EXECUTIVE OFFICER
◾ Company Name: Inoviq
◾ Company ASX code: IIQ
◾ Key areas: Biotechnology – diagnostics and therapeutics
◾ Key Personnel: Dr Leearne Hinch, CEO | Dr Gregory Rice, CSO | Mark Edwards, CFO & Company Secretary
◾ Market Cap as of 31 July 2024: $64.51M
◾ 52 Week share price low/high: $0.465 - $0.920
◾ Website: inoviq.com
Inoviq is taking a two-pronged approach to developing next-generation tools for both cancer diagnostics and therapeutics, whilst deriving revenue from the burgeoning medical research sector.
The company is currently advancing clinical-stage diagnostics for detecting and monitoring ovarian and breast cancers and an early-stage therapeutics program for solid tumours.
Inoviq CEO Dr Leearne Hinch says investors are excited by the company’s recent advances across its multi-faceted exosome portfolio.
Exosomes are small packages released
“Inoviq also has an exosome-based ovarian cancer diagnostic in development with the University of Queensland, as a screening test for high-risk women.”
by all cells, including immune cells, that carry messages that regulate the function of other cells.
“Inoviq’s exosome platform includes multiple technologies, one for isolating exosomes for diagnostic use and another for isolating them for therapeutic use,” she says.
In June, Inoviq announced proofof-concept data for its exosome therapeutics program, showing its engineered exosomes targeted and killed breast cancer cells in vitro.
Inoviq’s exosomes are derived from immune cells that are genetically engineered to target and kill breast cancer cells.
Inoviq’s research tool, EXO-NET, is used by academia, diagnostic and drug companies to further their exosome research.
“We put our technology in a box so researchers can use the tech to capture exosomes, discover biomarkers and develop diagnostics,” Hinch says.
“The global exosome research market is expected to reach $US660 million by 2026.”
In April, the company expanded an existing agreement with Promega, by which the life sciences giant distributes EXO-NET globally.
“We also provide exosome research services that could lead to development of exosome diagnostics from which Inoviq could earn licensing fees and revenue,” Hinch says.
Inoviq also has an exosome-based ovarian cancer diagnostic in development with the University of Queensland, as a screening test for high-risk women.
The test consists of a number of “informative” biomarkers that are combined in a proprietary algorithm to give a cancer score.
Inoviq’s most advanced program is a
non-exosome breast cancer monitoring test, called SubB2M/CA15-3.
SubB2M is an engineered protein that detects a sugar biomarker that is present on many cancers.
“This test uses an antibody to capture the protein from the blood. SubB2M then detects the sugar hanging off the protein to make the test more sensitive and specific,” Hinch says.
In February, the company said that a 483-sample clinical validation study detected more than 80% of breast cancers across all stages and a monitoring study identified 19% more cancers than a leading approved test.
The company intends to secure potential commercial partners, in view of a US commercial rollout.
Hinch urges investors to keep their eyes on its highly promising exosome story.
Upcoming milestones include results from the exosome ovarian cancer study, additional in-vitro data from the exosome therapeutic program and securing a potential partner for SubB2M diagnostics.
The company also expects an uptick in both distributor and direct research sales.
After a recent capital raising, Inoviq has cash of approximately $13 million –enough to fund the company’s current development slate.


LEE RODNE EXECUTIVE CHAIRMAN
◾ Company Name: LTR Pharma
◾ Company ASX code: LTP
◾ Key areas: Emerging pharmaceutical company –erectile dysfunction
◾ Key Personnel: Lee Rodne, Executive Chairman
◾ Market Cap as of 31 July 2024: $108.74M
◾ 52 Week share price low/high: $0.235 - $1.050
◾ Website: ltrpharma.com
Best known by the brand names of Viagra and Cialis, the current oral treatments for erectile dysfunction have enormous disadvantages.
About 30% of men report side effects such as vomiting, diarrhoea and dizziness. Users are required to fast and wait for an hour – after which the moment of ardour may well have passed.
“They get frustrated when the treatment doesn’t work straight away,” says LTR Pharma executive chairman Lee Rodne.
“As a result 50% of men stop purchasing Viagra because it doesn’t
work when they need it to.”
“According to research house Frost and Sullivan, more than 320 million men suffer erectile dysfunction globally –about 40% of men aged 40 to 70.”
The recently-listed LTR Pharma sniffs an opportunity to disrupt the $US3.8 billion ($5.5 billion) a year market, with a nasal spray that allows faster and safer delivery of the same underlying drug.
The drug candidate, Spontan is a nasal form of vardenafil, which sells in tablet form as Levitra and Staxyn.
As with Viagra, Spontan is a phosphodiesterase-5 (PDE5) inhibitor, which helps blood vessels to relax and increase blood flow to the penis.
“The nasal cavity is a highly vascular part of the body, supporting even and rapid absorption of the drug, empowering it to work within ten minutes or less,” Rodne says.
Given vardenafil has been approved, the safety profile is well established. In order for Spontan to get the green light, LTR Pharma carried out a small ‘bioequivalence’ study comparing Spontan to the oral tablet.
After fasting for a day, half of the 18 enrolees took Spontan and the other half took the tablet. “On the third day they swapped the treatments, enabling a true per-person comparison,” Rodne says.
“We didn’t have to prove that the drug itself works, but to prove that it gets into the bloodstream,” Rodne says.
In June, the company said the trial showed a significantly faster onset of action, reaching peak concentration in as little as nine minutes compared to 56 minutes for oral PDE5 inhibitors.
The nasal spray delivered the same therapeutic effect at half the dose of oral treatments, with comparable maximum drug concentration.
Rodne hopes the trial results will
support a marketing application to the US Food and Drug Administration or the local Therapeutic Goods Administration (under the agency’s early access gateway).
While working for Andrew Forrest’s healthcare arm, LTR Pharma executive chair Lee Rodne acquired the rights to the asset which was owned by a Californian research body.
LTR Pharma listed on December 11, 2023, raising $7 million at $0.20 per share.
Rodne says Spontan has the ability to disrupt the current market, which is still dominated by Viagra despite the drug being off-patent.
According to research house Frost and Sullivan, more than 320 million men suffer erectile dysfunction globally –about 40% of men aged 40 to 70.
“We are tackling a massive global market with a better, faster, and more efficient product that works when a guy wants it to work,” Rodne says.
For investors, LTR Pharma offers access to what would be the world’s first – and only – nasal spray for the condition.



DR THOMAS DUTHY EXECUTIVE DIRECTOR
◾ Company Name: Neurotech International
◾ Company ASX code: NTI
◾ Key areas: Biopharmaceutical – paediatrics
◾ Key Personnel: Dr Thomas Duthy, Executive Director
◾ Market Cap as of 31 July 2024: $71.21M
◾ 52 Week share price low/high: $0.043 - $0.125
◾ Website: neurotechinternational.com
While most drug developers don’t want to draw attention to a rival product, paediatric rare diseases house Neurotech International is proud to be compared with its $2.5 billion market cap ASX peer Neuren Pharmaceuticals.
Neuren shares surged after the company last year won US Food & Drug Administration (FDA) approval for its Rett syndrome treatment, Daybue.
Neurotech is tackling the same rare genetic disease, which results in behavioural and development difficulties in girls. The company also has mid-stage clinical programs in autism and the rare
“Neurotech is tackling the same rare genetic disease, which results in behavioural and development difficulties in girls.”
paediatric condition PANDAS-PANS.
Neurotech executive director Dr Tom Duthy says there’s room in the market for more than one Rett syndrome drug. In any event, Neurotech’s cannabinoidbased treatment could prove superior in terms of both efficacy and reduced side effects.
“I’m not put off that Daybue is the standard of care in the US,” he says. “That shows there is an accepted regulatory pathway for Rett syndrome. They have broken the soil for us and there is nothing wrong in being a fast follower.”
Neurotech’s lead compound NTI-164 derives from a cannabis strain with low levels of the psychoactive component THC and a novel combination of other cannabinoids, mostly CBDA.
In May, the company announced encouraging results from a local, 14-patient Phase-1/2 Rett syndrome study, comparing the girls’ conditions to a baseline score.
On the standard Clinical Global Improvement (CGI) score, the subjects at 12 weeks had improved an average 10% from a baseline of 4.6 points.
But on four selected measures –including communication skills and mental alertness – the improvement averaged 23%. These will be the focus for further clinical development.
In April the company unveiled results from its 54-patient Phase-2/3 autism trial, which showed a statistically significant improvement across multiple measures at eight weeks versus placebo.
The enrollees were classed as either level two (requiring substantial support) or level three (very substantial support).
Similarly, a 15-patient Phase-1/2 PANDAS-PANS trial reached its primary endpoint of a 30% reduction in anxiety
and depression at 12 weeks, with follow-up results at 52 weeks showing a “highly significant and clinically meaningful” 45% improvement.
PANDAS (paediatric auto-immune neuropsychiatric disorders associated with streptococcal infections) and PANS (paediatric acute-onset neuropsychiatric syndrome) is manifested in children going to bed but waking up with heightened anxiety and depression and obsessive compulsive behaviour.
Duthy says the company is considering its options in terms of furthering trials across all three indications. Commercialisation options include licensing or partnering – a funding strategy successfully executed by Neuren.
Duthy says one “well designed” trial could get the Rett syndrome and PANDAS/PANS indications to the point of registration.
The company is not targeting US approval in the short term. But Duthy says NTI-164 could be used in combination with Daybue for Rett syndrome, or a ‘second-line’ therapy for girls who stopped taking Daybue because of unpleasant side effects.
“We now have a bona fide clinical development pipeline,” Duthy says.



TOM SPURLING CEO & EXECUTIVE DIRECTOR
◾ Company Name: Nova Eye Medical
◾ Company ASX code: EYE
◾ Key areas: Medical technology – glaucoma treatment
◾ Key Personnel: Tom Spurling, CEO & Executive Director | Victor Previn, Executive Chairman | Kate Hunt, Chief Commercial Officer
◾ Market Cap as of 31 July 2024: $54.91M
◾ 52 Week share pricelow/high: $0.111 - $0.316
◾ Website: nova-eye.com
Nova Eye’s simple ‘vision’ statement is to improve treatment for the world’s 140 million sufferers of the debilitating eye disease glaucoma.
Nova Eye’s lead device iTrack microcatheter is used for canaloplasty surgery, to reduce the intraocular eye pressure in glaucoma patients.
The single-use iTrack has three components; a light for navigation, a wire and a pipe to transport liquid for flushing Schlemm’s canal, the eye’s ocular irrigation system that circulates nutrients.
“Typically blockages in the ocular irrigation system occur progressively
“Nova Eye’s lead device iTrack microcatheter is used for canaloplasty surgery, to reduce the intraocular eye pressure in glaucoma patients.”
in people with glaucoma,” CEO Tom Spurling says. “While glaucoma is incurable, the progression can be slowed.”
Approved in the US and the European Union and other countries including China and Germany, iTrack has been used in more than 130,000 procedures.
In April last year, the company obtained US Food and Drug Administration (FDA) approval for a refined version, iTrack Advance. The key difference is a pencil-like handpiece that enables surgeons to guide the catheter with a thumb or forefinger.
iTrack Advance was launched in Europe in mid-2022 and in the US in April 2023. The swift uptake of the device saw iTrack sales grow 37% to US$15.3 million ($23 million) in the year to June 30 2024, with US sales vaulting 75% to US$11.4 million.
Spurling says that with a doubling of the company’s US sales team to ten reps, the current run rate is US$18 million in an addressable market for glaucoma surgical devices of US$743 million (forecast to reach US$1.341 billion by 2028).
Nova Eye’s sales growth is also translating to the bottom line, with the glaucoma segment expected to drive a “material improvement” on last year’s US$4 million loss.
While Nova competes with other glaucoma surgical device suppliers, Spurling says the key benefit of the “elegantly designed” iTrack is that it leaves nothing behind in the eye.
“Every other device on the market either cuts or damages the canal by removing tissue, or it inserts a metallic stent to hold everything open,” he says.
“Our devices flush the ocular irrigation system and leave the body to its natural processes.”
Spurling says glaucoma can be treated with daily drops, but about half of patients are non-compliant with their medications.
“Hopefully we can reduce the need for patients to put drops in their eye all the time.”
Nova Eye is also developing 2RT, potentially the world’s first laser therapy for the equally debilitating age-related macular oedema (AMD).
The 2RT program has been set up in a special-purpose subsidiary AlphaRET Pty Ltd.
Given the company’s priority clearly is glaucoma – especially the US rollout – it will seek a funding partner to develop this asset.
Nova Eye evolved from Ellex Medical Lasers, which sold most of its business (lasers and ultrasounds) to French outfit Lumibird for $100 million.
The company is Adelaide headquartered and carries out its research and development there, but US activities take place out of Fremont, California.
In March, Nova Eye raised $8 million in a rights offer supported by institutions including the company’s biggest shareholder Australian Ethical.



DR FREDERIC GUERARD CHIEF EXECUTIVE OFFICER
◾ Company Name: Opthea
◾ Company ASX code: OPT
◾ Key areas: Biopharmaceutical – treatment for eye disease
◾ Key Personnel: Dr Frederic Guerard, CEO
◾ Market Cap as of 31 July 2024: $510.9M
◾ 52 Week share price low/high: $0.430 - $0.440
◾ Website: opthea.com
Opthea’s corporate vision is a literal one: to improve the eyesight of millions of sufferers of the common eye disease wet age-related macular degeneration (wet AMD).
Listed on both the ASX and Nasdaq, Opthea is undertaking two large PhaseIII trials pitched at US Food & Drug Administration (FDA) approval for its novel treatment.
The leading cause of blindness among the over 50s, wet AMD is caused by blood vessels growing abnormally under the retina. Patients can lose vision in as little as ten weeks.
“The leading cause of blindness among the over 50s, wet AMD is caused by blood vessels growing abnormally under the retina. Patients can lose vision in as little as ten weeks.”
Known as OPT-302, Opthea’s drug candidate sozinibercept blocks the activity of two Vascular Endothelial Growth Factor (VEGF) proteins contributing to the disease: VEGF-C and VEGF-D.
If successful, sozinibercept would be the first superior new treatment in 15 years for wet AMD, which affects about 3.5 million people in the US and Europe alone. The treatment market currently is worth around $US15 billion per annum.
Opthea CEO Dr Frederic Guerard says existing therapies only block VEGF-A, leaving about 60% of patients with sub-optimal results.
Enrolling close to 1000 patients each, Opthea’s two global trials, COAST and shORe are designed to assess the safety and superior efficacy of sozinibercept in combination with standard-of-care antiVEGF-A therapies (Lucentis or Eylea) compared to standard of care alone for the treatment of patients with wet AMD.
Top-line data from COAST is expected in the 2025 June quarter, with the shORe results expected in mid-2025.
Guerard says the trials only need to emulate the results of an earlier, 366-patient Phase-II study, showing a combination treatment was significantly more effective than the standard-of-care drugs alone.
These results showed patients read 14.2 more letters on an eye chart, a mean 3.4 more than those on the current therapy alone.
“The Phase-III trials are very well powered to show that statistical superiority again,” Guerard says. “I am very confident the trials are designed to maximise the chance of success.”
Guerard says the company is targeting a launch in the US first not only because of the size of the market, but because reimbursement (insurance) procedures
are well-established and fast.
He says Opthea is likely to take a ‘goit-alone’ approach in the US, rather than entering a partnership.
“The US market is actually pretty straight-forward because it’s very concentrated across very high-volume clinics.”
The Opthea story highlights the huge cost of blockbuster drug development, with the company turning to the market several times for large amounts.
Guerard acknowledges Opthea’s valuation has been impacted by earlier trial delays and the financing strategy “not originally matching the needs of the company.”
After a current $227 million underwritten rights issue Opthea will have enough cash to last for more than a year and – significantly – beyond the trial data read-outs.
The trials include patients with a wet AMD variant called polypoidal choroidal vasculopathy (PCV), prevalent in Asian populations.
Guerard says when Lucentis entered the Australian market a decade ago, the drug achieved $300 million of peak annual sales.
“There are no small markets for these diseases – they are all attractive,” Guerard says.



DR CAMILE FARAH CEO & MANAGING DIRECTOR
◾ Company Name: Optiscan Imaging
◾ Company ASX code: OIL
◾ Key areas: Medical technology – Digital pathology hardware and software
◾ Key Personnel: Dr Camile Farah, CEO & Managing Director | Brendan Fafiani, COO | Darius Ooi, Finance Manager
◾ Market Cap as of 31 July 2024: $179.59M
◾ 52 Week share price low/high: $0.071 - $0.260
◾ Website: optiscan.com
Optiscan Imaging’s mission is to ensure that painful and frequently unnecessary biopsies don’t remain the standard of care for detecting cancer and other diseases.
With an eye on the US market, the company is also developing devices to improve surgical and pathology workflows.
A leader in confocal laser endomicroscopy, Optiscan seeks to eliminate the age-old and unreliable method of analysing tissue samples under a traditional microscope.
Optiscan’s underlying digital ‘platform’ technology has applications including
“Optiscan has developed a pen-like, handheld 3D digital imaging tool, enabling clinicians to make quick, real-time treatment decisions.”
in surgery, pathology, life sciences and veterinary clinics.
The company’s initial focus is on human oncology, which Optiscan CEO Dr Camile Farah dubs a “huge addressable market with numerous clinical issues to solve.”
Optiscan has developed a pen-like, handheld 3D digital imaging tool, enabling clinicians to make quick, realtime treatment decisions.
The company’s first device is called InVivage. It’s designed for oral cancer surgeons, but that’s only the start.
“We want InVivage in the hands of dentists, oral health therapists and oral physicians because it can be used to monitor patients as well as diagnose cancers,” Farah says.
In June the company also revealed InVue, an in-surgery device enabling surgeons – and remote pathologists - to gain real-time insights and make onthe-spot decisions.
“If they are removing a tumour, they will use the probe on the tumour bed once the surgery is done,” Farah says. “A pathologist can be on a telepathology consultation and review the images if required.”
Initially the company is targeting lumpectomies, which account for twothirds of breast cancer surgery – the remainder are mastectomies.
To support an eventual US Food & Drug Administration (FDA) marketing application the company plans two lumpectomy studies, one local and one in the US.
Optiscan also will announce a third product to move pathology labs away from cumbersome manual processes and into the digital era.
“It is a true pathology laboratory device whereas InVue is a surgical device,” Farah says.
“It will enable surgeons and pathologists to work together, but with
more of a pathology-focused workflow compared to InVue.”
Meanwhile, the company is communicating with the FDA on how best to advance marketing applications for its unapproved devices.
Farah says investors can expect significant milestone achievements and news flow over the next 12 months, including the pathology product ‘reveal’ and the cloud-based telepathology platform to be completed in early 2025.
The company is working with the esteemed Mayo Clinic of the US to build an imaging platform for surgical robots, which – unlike many surgeons’ hands –won’t move a millimetre out of place.
With a $3 million Australian government grant, the company is also developing a flexible endoscope for gastrointestinal use.
The company is also eyeing a clinical partnership in the small animal veterinary sector, “which has similar issues to human health.”
While the company in effect is prerevenue from its clinical solutions, it derives useful income from its legacy life sciences product ViewnVivo, sold to big pharma and medical research institutions.
Under a long-standing tie-up, Optiscan also sells neurosurgery devices to German optics house Carl Zeiss on a ‘white label’ basis.



PHILIP DAFFAS CEO & MANAGING DIRECTOR
◾ Company Name: PainChek
◾ Company ASX code: PCK
◾ Key areas: Medical technology – pain assessment
◾ Key Personnel: Philip Daffas, CEO & Managing Director
◾ Market Cap as of 31 July 2024: $65.43M
◾ 52 Week share price low/high: $0.025 - $0.070
◾ Website: painchek.com
With its novel app-based digital tool, PainChek gives a voice to nursing home residents and infants who can’t otherwise enunciate their pain.
PainChek believes that if pain can be correctly assessed, it can be treated properly.
These claims are backed by recent medical publications showing the use of PainChek in aged care has resulted in better use of pain relief, reduced use of anti-psychotic drugs and sedatives and improved overall well-being for the residents.
The eponymous device works by scanning a patient’s face for three
“After a recent $5 million equity raising, PainChek is well placed to execute its multi-faceted expansion plans.”
seconds with a mobile phone camera and measuring the nine facial indicators of pain. It then guides a carer through a series of observational assessments to produce a pain score and severity rating.
“PainChek combines artificial intelligence with human intelligence to help carers better assess their residents’ pain and deliver better clinical results,” PainChek CEO Philip Daffas says.
“This also makes the residents’ loved ones much happier.”
To date, five million clinical PainChek tests have been carried out across 1600 aged-care facilities, accounting for 90,000 bed licences mainly here and in the UK (the company has a smaller presence in New Zealand and Canada).
PainChek’s local reach covers around 60,000 beds – 21% more than a year ago and equating to a 30% market share.
In the UK the company accounts for 30,000 beds in a market of 450,000 beds, with its market penetration doubling over the last year.
But bigger markets beckon.
In the US, the company has successfully completed a study to support a marketing application to the US Food & Drug Administration.
The study tracked circa 100-patients across five nursing home sites, in Iowa and New York. The locations were chosen to represent a range of populations and skin colours, thus confirming the device’s universal applicability.
In North America, PainChek is partnered with electronic medical record (EMR) provider PointClickCare, which covers 50% of the two-millionbed US market.
“We are also looking to work with other partners to cover the rest of the market, both for integration and reselling opportunities,” Daffas says. Meanwhile, the infant market is a
global opportunity of 400 million preverbal children.
In Australia the company is poised to ‘soft launch’ the device by signing up about 100 first-time parents initially.
“As we get that marketing mix right, we will finalise the product and release it through the app store as a direct-toparent product,” Daffas says.
In aged care, PainChek has been in contact with potential integration and distribution partners in mainland Europe, including Germany, France and Scandinavia.
PainChek is also eyeing the hospital market, having agreed to a pilot with Edinburgh Royal Infirmary. The company has also completed a related technology integration with EMR provider InterSystems, in view of a global hospital market partnership.
After a recent $5 million equity raising, PainChek is well placed to execute its multi-faceted expansion plans. The company’s in-place contracts are worth $4.5 million in annualised recurring revenue.
“We would look to achieve the same aged-care penetration in the US as in Australia,” Daffas says.
“But just 1% penetration of the global infant market would equal the entire aged-care opportunity.”



PAUL RENNIE FOUNDER, EXECUTIVE CHAIR & MANAGING DIRECTOR
◾ Company Name: Paradigm Biopharmaceuticals
◾ Company ASX code: PAR
◾ Key areas: Biopharmaceutical – late stage musculoskeletal disorders
◾ Key Personnel: Paul Rennie, Founder, Executive Chair & Managing Director | Dr Donna Skerrett, Chief Medical Officer and Executive Director
◾ Market Cap as of 31 July 2024: $91.09M
◾ 52 Week share price low/high: $0.210 - $0.919
◾ Website: paradigmbiopharma.com
Paradigm Biopharmaceuticals is at the pointy end of commercialisation of a new treatment for knee osteoarthritis (OA), the most common musculoskeletal disorder that affects more than half a billion people aged over 45 globally.
The company is waiting for assent from the US Food & Drug Administration (FDA) to launch a pivotal Phase-III trial, while it is also eyeing early provisional marketing approval from the local Therapeutic Goods Administration (TGA).
Paradigm is repurposing injectable pentosan polysulfate sodium (iPPS), trademarked as Zilosul, which has been
“Paradigm Biopharmaceuticals is at the pointy end of commercialisation of a new treatment for knee osteoarthritis.”
used as a veterinary OA drug and to treat a human bladder condition and deep-vein thrombosis.
Derived from beechwood, PPS has been long known for its antiinflammatory, analgesic, and antithrombotic properties, without the addiction drug issues associated with opioids.
To date, more than 600 patients have used Zilosul under the TGA’s special access scheme – including Australian Rules footballers and Australian basketballers.
“We had some fantastic feedback from that, with doctors saying that 80% of patients benefited,” says Paradigm founder and managing director Paul Rennie, who himself has undergone the treatment.
While this ‘real world’ evidence is compelling, drug regulators demand structured trials before they consider any new therapy.
Last October, Paradigm reported the results of a 61-patient Phase-II study, exploring Zilosul’s effect on knee pain and function as well as its diseasemodifying characteristics via biomarker analysis of synovial fluids and MRI imaging.
At the optimal dose, the results showed a significant reduction of pain at 12 months, along with a fivefold reduction in the use of rescue medication (generally paracetamol and oral anti-inflammatories).
A further MRI analysis suggests Zilosul may even reverse the knee damage – rather than deal with the symptoms – with improved cartilage thickness, volume and reduced bone marrow lesions at six months.
After a dose-ranging study of moderate to severe knee OA patients, Paradigm selected the optimal dose for the next stage (two milligrams per kilogram of bodyweight, injected twice weekly for six weeks).
Having envisaged enrolment of 500 patients, the company now believes a reduced number of candidates would be adequate to achieve statistical significance.
With the compound subject to FDA fast-track status, the company expects swift approval of the trial, with an interim analysis of the 12-month data expected in 2026.
Meanwhile, Paradigm recently filed an initial determination application to the TGA for approval to proceed with an application for provisional approval of Zilosul, which could pave the way for early revenues from 2026.
The provisional approval mechanism is available to drugs that meet an unmet need and demonstrate efficacy above and beyond any current treatment.
Funding-wise, Rennie says the company has several levers to augment its $26 million of cash in the bank as of the end of March, including a potential licensing agreement.
Rennie also notes the size of the US prize, with a modest 5% market penetration representing a $US5 billionplus revenue opportunity.
“We have been beaten down, share price-wise,” he says. “However, the company continues to make significant progress which could change investor sentiment quickly on the back of the important upcoming milestones.”



JAMES GARNER CEO & MANAGING DIRECTOR
◾ Company Name: Percheron Therapeutics
◾ Company ASX code: PER
◾ Key areas: Biotechnology – clinical stage novel therapies
◾ Key Personnel: James Garner, CEO & Managing Director | Deborah Ambrosini, CFO | Dr Cathryn Clary, Chief Medical Advisor
◾ Market Cap as of 31 July 2024: $63.10M
◾ 52 Week share price low/high: $0.050 - $0.110
◾ Website: percherontx.com
Percheron Therapeutics is being referred to as ‘the next Neuren Pharmaceuticals’, a reference to its ASX peer which developed an approved treatment for a rare childhood neurological disorder.
While Neuren’s approved drug treats Rett syndrome, Percheron is targeting the slightly-less-rare Duchenne muscular dystrophy (DMD), which affects about 300,000 boys and young male adults globally.
Percheron CEO Dr James Garner confirms that Neuren’s experience is the template for what Percheron – previously known as Antisense
“Investors will not have to wait long for results: initial (top-line) data is due in December 2024, with final data expected to be unveiled by the end of 2025.”
Therapeutics – would like to achieve.
“They have done exactly what we aspire to do,” Garner says. “They have partnered the drug with a bigger company, it is a commercial product and Neuren is a multibillion-dollar business.”
DMD is caused by a mutation in the dystrophin gene, leading to severe progressive muscle loss and premature death. Current treatments, mainly corticosteroids, have limited efficacy and significant side effects.
A so-called antisense oligonucleotide, Percheron’s lead compound ATL-1102 inhibits the inflammation caused by the lack of the dystrophin protein.
One of Australia’s oldest biotechs, Percheron initially targeted multiple sclerosis (MS).
While MS is much more common and an early trial showed efficacy, there are more treatment options and management decided that pursuing DMD would be more fruitful.
In May the company said it had completed recruiting for a Phase-2b trial, with 48 wheelchair-bound DMD boys enrolled across 16 hospitals in five countries.
The trial design involves boys being randomly allocated into one of two dosage groups, or a saline injection placebo.
But no patient misses out: after six months, the placebo group is reallocated to one of the active treatment arms.
The study’s primary endpoint is the change in upper limb function at six months, as measured by the standard Performance of Upper Limb (PUL2.0) score.
Investors will not have to wait long for results: initial (top-line) data is due in
December 2024, with final data expected to be unveiled by the end of 2025.
The company hopes the data will emulate the “very promising” results of an earlier nine-boy study, carried out at Melbourne’s Royal Children’s Hospital.
Garner says the company has an open mind on the next steps, which could be a larger Phase-III study pitched at FDA approval – although it is possible the agency would not require a further trial.
“There are a lot of ways this can unfold and hopefully a lot of options open up for us along the way,” he says.
As of the end of March, Percheron had $14.9 million in the bank, enough to last well into calendar 2025 and beyond the data read-out.
“But we have been very clear we won’t take the drug to market ourselves. The best chance of maximising success is to put it in the hands of a bigger company, and we are already speaking to interested parties,” Garner says.
As with Neuren, a rare disease does not mean an unprofitable one: Percheron estimates the current size of the DMD treatment market at $US4 billion per annum, given the “favourable pricing dynamics”.



DR MICHAEL THURN CEO & MANAGING DIRECTOR
◾ Company Name: PharmAust
◾ Company ASX code: PAA
◾ Key areas: Biotechnology – human neurodegenerative diseases
◾ Key Personnel: Dr Michael Thurn, Managing Director & CEO | John Clark, COO
◾ Market Cap as of 31 July 2024: $97.22M
◾ 52 Week share price low/high: $0.067 - $0.535
◾ Website: pharmaust.com
The notion that ‘everything old is new again’ applies not just to fickle fashion trends, but to drug development with a number of ASX-listed biotechs dabbling in reformulations.
In the case of PharmAust, the company is reviving an old animal drug called monepantel to tackle the difficultto-treat motor neurone disease (MND), also known as amyotrophic lateral sclerosis (ALS).
If the stars align, the drug could be on the market in less than three years.
“In a light bulb moment monepantel turned from being a sheep dip to
“PharmAust announced top-line results of a 12 patient Phase-I study, dubbed MENDS, showing a 58% reduction in disease progression for the high-dose cohort.”
something useful for humans,” PharmAust CEO Dr Thurn says.
Affecting about 350,000 people globally, the invariably fatal MND is a nervous system disease that weakens muscles and impacts physical function.
Well known sufferers include the late physicist Stephen Hawking and AFL footballer Neale Daniher, founder of the Big Freeze fundraiser.
There are two other drugs on market – a third one was taken off market – but are only able to prolong life by up to six months.
PharmAust first identified monepantel’s potential to treat MND after pre-clinical studies found the drug could induce autophagy (orderly degradation) of in diseased cells.
In February this year, PharmAust announced top-line results of a 12 patient Phase-I study, dubbed MENDS, showing a 58% reduction in disease progression for the high-dose cohort.
Delivered over 12 months, the dosage was also well-tolerated with no serious side effects.
Monepantel’s active agents were detected in certain biomarkers in the cerebrospinal fluid, showing they can cross the protective blood-brain barrier.
In June the company reported 10 out of 12 of these Phase-I patients would participate in an open label phase expansion study.
The company also outlined additional analysis, showing “significantly longer survival” compared to matched control from a pooled database of 16 clinical trials and one observational trial.
The company hopes to carry out a Phase-2/3 global study aimed at accelerated approval from the US Food and Drug Administration.
Costed at $25-30 million, the trial
would enrol around 200 patients.
“We are well advanced in the trial design and the regulatory nuances associated with making sure we have the clearest path to accelerated approval,” Dr Thurn says.
In May the FDA conferred orphan drug status for monepantel. This allows for tax credits, potential grants, waived clinical fees and seven years’ exclusivity from generic and branded competition.
Despite efficacy questions about the approved therapies, the MND treatment market was more than $US6.7 billion in 2023 and is forecast to reach $US11.8 billion by 2034.
The treatments cost between $US150,000 and $US200,000 per annum.
PharmAust evolved from the shell of Echo Technologies, which listed in 2001.
The company acquired the monepantel rights via the purchase of the private Pitney Pharmaceuticals in 2015.
PharmAust initially focused on human and animal cancers, but pivoted to MND after receiving an $880,000 grant from Fight MND, the charity behind the Big Freeze.
Dr Thurn says PharmAust’s tighter commercial strategy is about finding a partner to fund the adaptive study, or an outright acquisition of the company.



DR DANIEL TILLETT CHIEF EXECUTIVE OFFICER
◾ Company Name: Race Oncology
◾ Company ASX code: RAC
◾ Key areas: Biopharmaceutical – oncology
◾ Key Personnel: Dr Daniel Tillett, CEO | Dr Peter Smith, Executive Director | Dr Michelle Rashford, Chief Medical Officer
◾ Market Cap as of 31 July 2024: $276.00M
◾ 52 Week share price low/high: $0.640 - $2.090
◾ Website: raceoncology.com
Race Oncology’s charter is to combine its ‘reimagined’ cancer drug called bisantrene with established chemotherapy, to achieve both greater anti-cancer efficacy and to avoid the common and severe side effect of heart damage.
“There are a number of cardioprotective drugs out there, but most of them don’t get used for different reasons,” says Race CEO Dr Daniel Tillett.
“And importantly there are none that offer both anti-cancer and cardioprotective properties in the one drug.”
“Race then found that combining bisantrene with the anthracycline doxorubicin offered ‘significantly improved cancer cell killing’ across a panel of 143 tumour cell lines.”
Bisantrene has a long history of safety and anti-cancer efficacy, supported by more than 50 trials in over 1500 patients.
The drug was approved by French regulators in 1988, but it was never sold due to formulation issues that resulted in the drug crystallising in the blood.
Anthracyclines are standard-of-care chemotherapy drugs used to treat more than 20 cancer types, but they come with the risk of serious and permanent heart damage.
“Our big discovery in 2022 was that you could combine bisantrene with an anthracycline and get the best of both worlds – improved anti-cancer activity plus protection of the heart,” Dr Tillett says.
Race then found that combining bisantrene with the anthracycline doxorubicin offered “significantly improved cancer cell killing” across a panel of 143 tumour cell lines, compared with either drug used alone.
“These results supported the [combination] as a potential treatment for solid tumours such as lung, prostate, pancreas, breast and head and neck cancer,” the company said.
Having initially eyed a US program for metastatic breast cancer but dismissed it as too expensive, Race is now preparing for a local “all comers” study for a range of solid cancers including breast cancer.
The company expects to recruit the first of up to 40 patients by the end of the year, across up to ten Australian sites.
The trial would combine a reformulated version of bisantrene called RC220, with doxorubicin.
Pending the results, the company
plans a $32 million follow-on trial in up to 120 patients, focusing on cardioprotection and anticancer activity.
Race also expects a leading local haematologist to lead an investigatorsponsored study for acute myeloid leukemia (AML).
Costed at $4 million, the trial would target up to 60 patients and would start in late 2024 or early 2025.
Following positive results from two Phase-II trials at Israel’s Chaim Sheba Medical Centre, the study will combine bisantrene with decitabine as a lowintensity treatment.
Historically, AML patients have been treated with high-intensity chemo followed by a bone marrow transplant, but about two-thirds of them are too ill to handle the serious side effects.
With more than $20 million in the bank and with $30 million of options due to be exercised before mid-2026, Race is well funded.
“For the dollars spent we get a lot of value out the other side, which is what Australian biotechs need to be about,” Dr Tillett says.
“You need to use your brain rather than your shareholders’ wallets by innovating and doing things differently.”



GARY PHILLIPS CHIEF EXECUTIVE OFFICER
◾ Company Name: Syntara
◾ Company ASX code: SNT
◾ Key areas: Clinical stage – biopharmaceutical oncology
◾ Key Personnel: Gary Phillips, CEO
◾ Market Cap as of 31 July 2024: $35.82M
◾ 52 Week share price low/high: $0.014 - $0.055
◾ Website: syntaratx.com.au
Syntara’s reason for being is to treat the inflammatory and fibrotic conditions at the heart of dozens of chronic health conditions.
Formerly known as Pharmaxis, the company commercialised two products: Bronchitol for cystic fibrosis and Aridol, a lung function test. But they weren’t the company makers as was expected.
Syntara has since turned back to the clinic with multiple trials centred on inhibiting pan-lysyl oxidase, an enzyme closely implicated in fibrosis and scarring.
Syntara has active programs for two lysyl oxidase inhibitors: SNT-5505 (for
“The company’s lead program is for myelofibrosis, a rare bone marrow cancer with about half a million sufferers globally who can expect to live for five years.”
myelofibrosis and myelodysplastic syndrome) and SNT-6302 (scarring). Another anti-inflammatory drug candidate, SNT-4728, targets Parkinson’s disease.
The company’s lead program is for myelofibrosis, a rare bone marrow cancer with about half a million sufferers globally who can expect to live for five years.
In December last year Syntara released interim Phase-2a results showing positive results for end-of-life patients who had failed other treatments, with half of the evaluable patients improving their fibrosis score at 24 weeks’ treatment.
The company has now launched a 15-patient follow-on trial combining SNT-5505 with a JAK (janus kinase) inhibitor. The standard of care, JAKs provide symptomatic relief but within five years, 75% of patients have discontinued treatment because of unpleasant side effects.
“Our drug does something about the underlying disease, so we have quite a different approach,” says Syntara CEO Gary Phillips.
The company expects to present interim results at December’s meeting of the American Society of Haematology, with a final readout next year.
The next step is a larger pivotal trial, aimed at US Food and Drug Administration approval.
Phillips notes blood cancer is a “hot area”, with mid-to-late stage assets changing hands for $US1.5 billion ($2.23 billion) or more.
“The big drug companies are looking for good drugs they can take forward because the unmet need is very high,” he says.
Meanwhile, Syntara plans to start recruiting for an externally-funded trial for another rare blood cancer,
myelodysplastic syndrome.
Separately, the University of Western Australia’s prominent burns surgeon Professor Fiona Wood is overseeing an investigator-led, 60-patient trial to treat scars resulting from surgery burns and other trauma.
Syntara is also collaborating on a trial to probe whether SNT-4728 can slow the progress of neurodegenerative diseases such as Parkinson’s disease.
Funded by Parkinsons UK to the tune of $5 million, the trial targets a sleep behaviour disorder that is often a precursor to Parkinson’s.
In a corporate tidy-up year, Syntara sold its unprofitable Bronchitol and Aridol business in return for royalty rights. The disposal saves $14 million a year in ongoing costs because of a reduced workforce, smaller premises and rent and insurance savings.
After a $10.3 million equity raising late last year, Syntara is cashed up until after the myelofibrosis data readout.
While Syntara shares have struggled to rise above their cash backing, recent sentiment has improved – as evidenced by the influx of institutional backers including Platinum Asset Management.
“This is not a ‘wait-and-see’ stock,” Phillips says. “Things are happening now.”



STEPHEN TOMISICH CEO & MANAGING DIRECTOR
◾ Company Name: Trajan Group Holdings
◾ Company ASX code: TRJ
◾ Key areas: Pharamaceuticals, life sciences, manufacture
◾ Key Personnel: Stephen Tomisich, CEO & Managing Director | Carl Beckett, Senior Vice President, Workflow | Nigel Gilligan, COO
◾ Market Cap as of 31 July 2024: $160.58M
◾ 52 Week share price low/high: $0.675 - $1.890
◾ Website: trajanscimed.com
In the scientific world, instruments need to deliver with extreme precision or the results can be costly in terms of compromised decision making affecting human health and environmental and food safety.
Trajan Scientific and Medical’s charter is to support thousands of such exacting instruments – or components – for dozens of applications including detecting contaminants in food and environmental samples, or in clinical diagnosis and pathology.
Trajan co-founder Stephen Tomisich says the company is about translating
“We operate with the major players across the whole workflow, from how you receive and prepare a sample to how it is measured in an instrument.”
science into tangible benefits.
“We often encountered scenarios where the technology and products existed, but it wasn’t converting into meaningful outcomes,” he says.
Both scientists, Tomisich and his wife Angela founded Trajan in 2011, having taken the risk of self-funding an anatomical pathology consumables business called Grale Scientific.
Six acquisitions later and still 100% self-funded, Trajan listed on the ASX in June 2021 as part of a $90 million IPO at $1.70 per share.
Five more purchases followed, the biggest being the $64 million purchase of the Kentucky-based Chromatography Research Supplies (CRS) in 2022.
“We went to IPO mainly because we had a number of targets getting ripe on the vine and we didn’t want to raise more personal debt,” Tomisich says.
Accounting for about two-thirds of annual revenue, or about $100 million, Trajan’s components and consumables arm includes gas and liquid chromatography and mass-spectrometry items.
Supplying equipment to the food and clinical and environmental testing sectors, capital equipment accounts for most of the remainder.
Then there’s the emerging ‘disruptive’ segment, in areas such as micro sampling and miniaturised portable instrumentation.
Tomisich says Trajan competes with numerous rivals, most of which are small, private regional-focused entities.
“We operate with the major players across the whole workflow, from how you receive and prepare a sample to how it is measured in an instrument,” he says.
Most of Trajan’s consumables revenue derives from proving bespoke componentry to names such as Thermo Fisher Scientific, Waters Corporation and Danaher Corporation.
On the capital equipment side, Trajan provides adjunct automated robotic platforms to streamline sampling processes.
The company remains headquartered in Melbourne but has facilities in Malaysia, Germany, North Carolina, Connecticut, Kentucky and Texas.
More than half of Trajan’s 650 staff work outside of Australia.
While Trajan still has an active acquisition pipeline, it is shoring up its balance sheet, including reviewing the ownership of five surplus properties – a legacy of the acquisitions – and excess inventory.
Tomisich says the company will climb the “hierarchy of value” by investing in emerging sectors such as blood micro sampling and focussing on automated workflows.
Trajan flagged that 2023-24 revenue would be subdued, partly because of weakness in the pharma segment and large customers winding back inventory post-pandemic.
“But green shoots are emerging and we hope to show more consistent revenue growth in 2024-25, in line with our past 13 years,” Tomisich says.
“If you have been in the industry for as long as me, you have seen these cycles play out before and ultimately conditions return to their long-term growth trajectory.”


